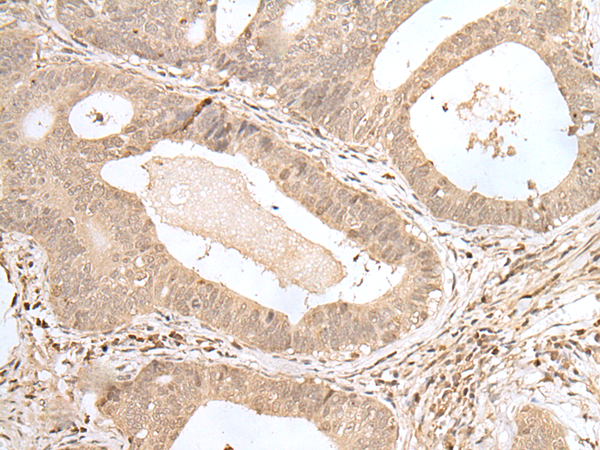

中文名稱:兔抗ZNF473多克隆抗體
|
Background: |
Involved in histone 3'-end pre-mRNA processing by associating with U7 snRNP and interacting with SLBP/pre-mRNA complex. Increases histone 3'-end pre-mRNA processing but has no effect on U7 snRNP levels, when overexpressed. Required for cell cycle progression from G1 to S phases. |
|
Applications: |
ELISA, IHC |
|
Name of antibody: |
ZNF473 |
|
Immunogen: |
Fusion protein of human ZNF473 |
|
Full name: |
zinc finger protein 473 |
|
Synonyms: |
ZN473; HZFP100 |
|
SwissProt: |
Q8WTR7 |
|
ELISA Recommended dilution: |
5000-10000 |
|
IHC positive control: |
Human gastric cancer and human thyroid cancer |
|
IHC Recommend dilution: |
25-100 |

購物車
購物車 幫助
幫助
 021-54845833/15800441009
021-54845833/15800441009
